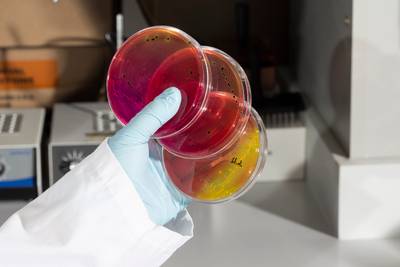

It wasn’t the hog nuts that made people sick. Nor was it the deer heart and noodles, elk meatloaf, turtle stew or any of the other fare served at the Swisher Men’s Club wild game feast in eastern Iowa in February 2019.
Matthew Arjes, an avid hunter, had gone to the event with some friends. It was for a good cause — the group raffled off rifles and fishing coolers to raise money for the local fire department.
But two days later, Arjes woke up with cold sweats and started vomiting. His fever spiked to 104 degrees. Drifting in and out of consciousness, Arjes spent the next four days in the hospital, battling salmonella and a life-threatening complication from the infection known as sepsis.
“It was the closest to death that I’ve been,” said Arjes, then 32.
Arjes was one of 115 people who reported illnesses after the dinner in Swisher, which is between Cedar Rapids and Iowa City, so state and local public health investigators interviewed victims and tested leftovers. The source of the food poisoning, they found, was the most ordinary thing on the menu — turkey, bought at a supermarket and smoked at somebody’s home for the event.
“Go figure,” Arjes said. “It’s a wild game feed dinner. There’s pretty much anything you can think of there, and the thing that got most people sick was turkey.”
Credit:
Jenn Ackerman + Tim Gruber
The event would turn out to be part of a nationwide outbreak of a rare type of salmonella known as Reading — except that this strain was far more virulent and less responsive to antibiotics, and it spread like wildfire through the turkey industry from 2017 to 2019. The outbreak led to recalls from grocery stores and to clusters of illnesses linked to potlucks like the one Arjes attended.
But it could have been far worse.
This fall, ProPublica reported that another strain of salmonella, known as multidrug-resistant infantis, has been running rampant through the chicken industry for nearly four years, sickening tens of thousands of people. The unchecked spread of infantis exposed stark gaps in the authority of the U.S. Department of Agriculture, which has little power to stop dangerous strains of salmonella from making people sick.
The Reading outbreak in the turkey industry underscored some of the same weaknesses in our food safety system, but the response to Reading offers a clear view of some potential fixes — and why they won’t be easy.
What made the critical difference was the turkey industry’s decision to take it upon itself to hunt down the virulent strain. The National Turkey Federation immediately formed a salmonella task force to fight Reading and developed a strategy that involved vaccination of breeding flocks, increased sanitation of turkey barns and changes in processing plants to reduce cross-contamination. Critically, several turkey companies also enlisted the help of outside researchers to better understand the strain’s seemingly sudden transformation.
It was a striking contrast to how the chicken industry has responded to infantis. The National Chicken Council has met with the Centers for Disease Control and Prevention several times to discuss infantis, but the CDC says the trade group has shared little with the agency about what it knows about the strain and its efforts to eradicate it.
“The industry runs the show on what information gets shared and what they are doing to clean up a problem,” said Thomas Gremillion, food policy director at the Consumer Federation of America. “We are at the whim of the industry and what they calculate is damaging to profits and what makes sense to deal with from a business perspective.”
So, while infantis has continued to proliferate in the chicken industry, the rate of Reading found in turkey during routine USDA sampling has gone down 73% since 2018, a ProPublica analysis found. And reports to the CDC of people getting sick from the strain have fallen by 65% compared with the outbreak period.
The U.S. chicken industry, led by some of the largest food companies in the world, has the size and political power to withstand the pressure of a public health crisis in its product. By contrast, the turkey industry remains relatively tightknit with top players who, while part of bigger food processors, remain primarily identified with turkey. It’s an industry whose image — and economic interest — has been carefully wrapped in the wholesomeness of annual holiday gatherings, while the chicken industry has pushed its way into almost every corner of the American diet.
Credit:
Jenn Ackerman + Tim Gruber
There are also vast differences in scale and the logistics of solving the salmonella problem. The U.S. produces more than 9 billion chickens a year across more than 25,000 farms and 200 processing plants. In comparison, the country produces about 225 million turkeys a year (40 times fewer) across 2,500 farms and 40 plants.
The USDA’s response to the outbreaks has been different too. After the CDC opened its Reading investigation, the USDA immediately notified the public of the outbreak and later released a review of its efforts. But almost four years into the infantis outbreak, the USDA still hasn’t said anything to consumers about infantis, which has become the most common type of salmonella found in chicken and is one of the biggest public health threats in a product the agency regulates.
The USDA didn’t respond to questions seeking comment for this article. But this year, senior public health officials at the agency told ProPublica that because they couldn’t link infantis to a single chicken product, they concluded there was nothing they could tell consumers that would be helpful.
The National Chicken Council told ProPublica that the industry has worked to address infantis, and the group provided a list of steps that companies take to control salmonella in general, including vaccinating breeding flocks against some strains. But it couldn’t identify many changes the industry has taken to address infantis specifically or industry efforts to research the strain.
The strains of infantis and Reading have a lot in common. Both seem to have emerged out of the blue, and by 2018, they had infected so many people that the CDC declared them outbreaks. Unlike most outbreaks that are tied to a specific product or processing plant, both strains became widespread in the supply chain, affecting dozens of companies. And both are resistant to multiple antibiotics, though infantis is far more difficult to treat.
The two strains also revealed that consolidation in the poultry industry, already a concern for business regulators, may be a public health problem, too. Following a string of acquisitions and partnerships in the past few decades, nearly all the chicken and turkey that the world eats now descends from birds bred by two chicken companies and two turkey companies. According to researchers, that concentration in poultry breeding appears to be leading to global epidemics of foodborne illness.
Yet regulators in the U.S. don’t have the power to focus their efforts further up the supply chain, food industry consultant Mansour Samadpour said. “There’s plenty of chances for salmonella to creep in at different stages,” he said, “but if it’s happening at the very top, then it’s a huge problem.”
The pervasive nature of Reading intrigued Tim Johnson, a poultry microbiologist at the University of Minnesota. In mid-2018, he began getting calls from veterinarians, farmers and others in the turkey industry. Something strange was happening. And they needed his help.
“I distinctly remember the first day that one of the vets from one of the companies came over and in not so many words told me, ‘We have a big problem on our hands,’” he said.
The proportion of Reading found in the company’s internal salmonella tests had more than doubled from a couple of years earlier, the veterinarian told him. People were starting to get sick from it. And they couldn’t figure out how to get rid of it. Some turkey farmers had resorted to tearing down barn walls and replacing them because they were still finding the bacteria after thorough cleaning.
Representatives from several companies came to the laboratory that Johnson worked out of in Willmar, Minnesota, in an old Spanish Colonial-style mental hospital that had been remade into a biotech center.
Up until then, Reading — which was first isolated in Reading, England, in 1916 — had been considered relatively benign. It had caused an outbreak in the U.S., mostly among children, in 1956-57, but since then, outbreaks had been rare.
The new strain was especially causing problems in ground turkey, where salmonella in general is found much more frequently. While USDA inspectors rarely detect salmonella in whole turkey during testing, last year they found it in 18% of ground turkey samples.
The companies wanted to know what was different about this Reading strain than the ones they’d seen in the past, Johnson said, and if there was something different, what could they do about it?
“I think it really opened their eyes to say we have to act on this as quickly and efficiently as we can and do more than we’ve done in the past to respond to it,” he said.
When he was younger, Johnson wanted to become a doctor, but a course in college got him hooked on studying disease-causing bacteria and led him to become a microbiologist. And having grown up in the state’s turkey-producing region in west-central Minnesota, Johnson knew turkey growers and kids who worked on poultry farms.
Credit:
Jenn Ackerman + Tim Gruber
“As I got older and started to see how the family farm seemed to be going away,” he said, “it really got me interested in how could I take what I know and what I do and apply that to work that would benefit farmers.”
So when the opportunity arose to come back home to the area and focus his research on turkeys, Johnson, 44, jumped at the chance. Johnson, who prefers casual clothes and work boots to the tucked-in button-downs of the stereotypical professor, quickly gained the trust of the region’s turkey farmers. He spent a sabbatical year working at a company that makes feed additives for turkeys and visiting farms to better grasp the challenges they faced with bacteria like salmonella.
To Johnson, investigating Reading was the kind of project the lab was designed for. Surrounding the campus is an expanse of farmland that’s home to more than 100 turkey operations.
The research would result in the development of a tool to identify new and risky strains of salmonella on farms and to stop them before they lead to outbreaks.
But first Johnson had to answer a question that puzzled him: How could a strain of bacteria come out of nowhere and sweep through the entire industry?
After the on-campus meeting, companies started bringing petri dishes streaked with salmonella to the lab in Willmar.
Johnson’s first task with Reading was to test some of the theories that had farmers and turkey companies spinning their wheels. His team found, for example, that this strain wasn’t any more resistant to the disinfectants used to clean barns than other salmonella. Nor was it any better at forming biofilms, which are kind of like slimy force fields that help bacteria stick to surfaces and make them harder to kill.
There was nothing about the barn environment that was causing the problem, Johnson said. Something else was going on. And to find it, they’d have to extract the bacteria’s DNA and examine its genome.
The turkey industry’s response to Reading differed from the chicken industry’s reaction to infantis almost from the beginning, when the two strains were identified in raw pet food.
A year before the wild game feast, a 2-year-old girl and her 4-year-old sister tested positive for salmonella. The 4-year-old’s infection was so severe that it had spread to her bones.
The girl’s parents had no idea how their daughters had gotten food poisoning, but investigators believe they might have picked the bacteria up while playing with the family dog, who was fed raw turkey pet food that contained the same strain of Reading that had made the girls sick.
While the USDA regulates meat and poultry, the Food and Drug Administration oversees almost all other foods, including pet food, and the FDA quickly announced a recall of the tainted dog food.
Within two weeks, the turkey industry responded. At its annual convention in February 2018, the National Turkey Federation recommended that its members stop supplying turkey to producers of raw pet food unless the companies had a way to kill the bacteria. The infantis strain had also spurred a raw dog food recall, but the chicken industry hasn’t told its members to stop working with the makers of what public health officials consider a potentially dangerous product.
“Having a bowl of raw meat on your floor is a bad idea, especially if you have kids,” said Carlota Medus, head of the foodborne diseases unit at the Minnesota Department of Health. “Your dog is not using utensils. They’re putting their face in their food. And then that face goes everywhere. So you’re basically going to cross-contaminate your kitchen, your living room, your hands.”
But the case was far from closed. There were two other Reading cases in Minnesota, and neither had a link to the dog food.
Medus’ team of epidemiologists had noticed small clusters of the strain popping up as far back as 2015. The new rise in Reading cases added to the mystery. Perhaps if they could trace back where the pet food company bought its turkey, they’d find a common supplier. But they couldn’t connect the dots.
So they searched a national database of foodborne bacteria samples, known as isolates. “And when we did that, we realized that there were highly related isolates all over the country,” Medus said.
Medus called the CDC’s outbreak response team.
A few months later, in July 2018, Lisa Wallenda Picard was in the middle of the turkey federation’s Summer Leadership Conference when the trade group got a call from the CDC, which was due to deliver an annual update to the industry. Executives from nearly every major turkey company were in a room at a Washington, D.C., hotel awaiting the presentation.
“As the CDC was getting ready to talk to us, we got a phone call that, ‘By the way, we’re gonna have to tell you guys there’s an outbreak,’” recalled Wallenda Picard, the group’s senior vice president of policy, trade and regulatory affairs. “And we’re like, ‘What?’ And I like to think I didn’t say any other words, but that’s probably not accurate.”
Medus’ tip to the CDC had checked out. Reading wasn’t just a problem in raw dog food. It was sickening people who’d eaten whole turkey and ground turkey and who worked in turkey plants.
As disturbing as the news was, it came at a fortuitous time, said Wallenda Picard, who perhaps fittingly comes from a famous family of tightrope walkers known as the Flying Wallendas.
“Everybody who needed to be there was literally in the room,” she said. “And we basically locked the doors and said: ‘All right, what the heck are we gonna do, people? This is a big deal.’”
Starting at that meeting and over the next several weeks, the turkey federation worked with public health experts and regulators to hammer out a list of more than 100 potential strategies from the hatchery to the grocery store to prevent salmonella.
The turkey industry could have chosen to ignore the outbreak. Neither the USDA nor the CDC have much power to make companies cooperate or to reduce salmonella.
But as a smaller sector with a narrower variety of products, the turkey industry faced greater risk from consumer pressure than the chicken industry did from infantis. “As a result of that, outbreaks, recalls really impact them more significantly,” said Brian Ronholm, food policy director for Consumer Reports. “And so there’s more of a collective approach to tackle the problem.”
As the industry began devising a plan, the Reading outbreak continued to grow. Health and agriculture officials in Arizona and Michigan collected packages of Jennie-O ground turkey from victims’ homes. Both tested positive for the outbreak strain.
The findings led Jennie-O Turkey Store to voluntarily recall about 310,000 pounds of ground turkey. The two recalls coming just days before Thanksgiving and Christmas created an image crisis not only for the brand, which is owned by Hormel Foods, but for the turkey industry as a whole.
“In the public realm, Jennie-O got blamed for a lot of this when, in fact, it was not solely their fault,” Johnson said. “The industry definitely realized that we’re all at risk here, not just a specific company.”
The USDA knew that Jennie-O wasn’t the only company with the Reading strain. Its inspectors had found the strain at plants owned by nearly all of the country’s major turkey producers. State health officials had found it in turkey products being sold at supermarkets under several different brands. And Canada had announced its own Reading outbreak, noting that none of the products recalled in the U.S. had been imported or distributed in the country.
But under the USDA’s rules, finding an outbreak strain in poultry plants wasn’t enough to recommend a recall. Nor was it enough to find it in raw meat on store shelves. It had to be tied to a specific patient who was already sick.
So, the outbreak continued.
The night of the Swisher Men’s Club wild game feast, about 225 people crowded into the American Legion hall in Swisher, sitting at long banquet tables. Most of the food on the menu had been hunted, trapped or caught. There were goose kabobs and rabbit sliders, pheasant Alfredo and even raccoon. But the club had also purchased about 20 turkey breasts from a supermarket.
Credit:
Jenn Ackerman + Tim Gruber
The menu didn’t faze Matthew Arjes. This was his third year going to the dinner. He had a plate of venison, fish and smoked turkey and tried the Cajun turtle.
The next day, he started feeling sick. “About 8 to 10 o’clock the following morning, I knew it wasn’t simple food poisoning,” said Arjes, who installs medical and dental equipment for a living. “It was full-fledged flu-like symptoms, extremely high fever, cold sweats, vomiting, diarrhea — the worst you could pretty much imagine.”
At the hospital in Cedar Rapids, Arjes was admitted to the intensive care unit. After the second or third day, he asked a nurse if he was going to live. “She’s like, ‘Well, we’ll just see how you feel,’” he recalled.
Arjes eventually recovered but was so fatigued from his bout with salmonella that he missed a month of work.
The Swisher Men’s Club worked with the state Health Department to identify the cause. Mike Brown, the group’s president, declined to comment but said the club decided to discontinue the game feast and host a catered banquet instead.
State investigators blamed cross-contamination and improper cooking, noting that a club member had only tested the temperature of half the smoked turkeys before putting them back into the same coolers that had been used to thaw and brine the raw turkeys.
Investigators also traced the turkey to a company that hadn’t been involved in the previous recalls. They notified the USDA, giving the agency another opportunity to take action to protect the public from Reading. Now that it knew the brand, the USDA could have issued a public health alert. Pulling the contaminated meat from stores would have required more evidence. But state records show the USDA “did not feel any regulatory actions were necessary” given the poor food handling.
The CDC closed its investigation into the nationwide Reading outbreak in April 2019, noting that 358 people had been infected and 133 hospitalized, including one person who died. But because the CDC estimates that for every confirmed salmonella case, about an additional 30 are never reported, more than 10,000 people had likely been infected by the outbreak. And since the strain was widespread, the CDC noted that “people could continue to get sick.”
Nearly a year and a half into the outbreak, it was clear that the source wasn’t the slaughterhouses. Just as in the infantis outbreak, it was somewhere higher in the supply chain in the turkey barns, feed mills or hatcheries. But the USDA’s Food Safety and Inspection Service, whose 8,700 employees are charged with ensuring meat and poultry is safe, doesn’t have the power to regulate or investigate salmonella on farms.
“One of the things that was really frustrating during this investigation was to see very clearly the limits of FSIS’ authority,” Medus said. “I mean something happened, and if something happened, it could be something that we can take action on to get this under control. But basically the response we were getting was: ‘Well, this reaches the limits of our authority. This is as far as we can take it.’”
The story of Reading could have ended up like the ongoing infantis outbreak — if not for the turkey industry’s work with Johnson. By looking at the genome, Johnson’s team was learning a lot about the Reading strain.
After samples of the bacteria had been sequenced at the lab in Willmar, Elizabeth Miller, a research scientist at the campus in St. Paul, began analyzing the genomic data in early 2019, looking for mutations that might explain how Reading had become so dangerous.
She gathered data on nearly 1,000 other Reading samples going back nearly 20 years and began mapping the evolution of the strain.
Reading had indeed changed. The strain had acquired a virulence gene that made it more invasive to humans. It then developed another mutation that made it better at fighting other bacteria in turkeys’ guts, a process known as “microbial warfare.” As the new version of Reading emerged, it picked up genetic elements called plasmids that contained genes that gave it resistance to several antibiotics.
Armed with this information, Johnson’s team tested the strain in the lab and confirmed what it had seen in the genome.
Credit:
Photographs by Jenn Ackerman + Tim Gruber
Studying the findings, the researchers concluded in a paper last year that the new Reading strain had to have come “from a common source, likely through supply birds at the top of the genetic breeding pyramid.”
Johnson noticed that the timing of the strain’s emergence coincided with an outbreak of bird flu that had decimated turkey breeder supplies in the Upper Midwest in 2015. Early that year, at a 15,000-bird breeder farm in Minnesota, turkeys were found gasping, spastically arching their heads and necks and flapping their wings. Within days, more than 70% of the birds died. The disease quickly spread to hundreds of farms, according to other University of Minnesota researchers, affecting about 50 million chickens and turkeys across the country.
“All of a sudden they had to replace everything all at the same time,” Johnson said. And because of the timing and small number of companies supplying the breeding stocks, the new Reading strain spread quickly through the turkey industry.
The theory about Reading’s origin was one in a series of recent findings linking the concentration of breeders to outbreaks. This summer, University of Georgia researchers traced the worldwide spread of another type of salmonella to the international trade of chicken breeding stocks. And the CDC has pointed to breeding flocks as a potential source of the infantis outbreak.
Cobb-Vantress, a chicken breeder owned by Tyson Foods, said in a statement to ProPublica that it had “significant questions on the approach taken by the studies and the validity of the conclusions drawn.” But the company didn’t detail its concerns. Aviagen, the other major chicken breeder, declined to comment. And neither of the major turkey breeders, Hendrix Genetics and Select Genetics, which is owned by Aviagen and Life-Science Innovations, responded to calls or emails seeking comment.
Johnson’s findings not only provided a probable origin story. It also presented an answer for how to defeat the strain.
“It turns out the only way to really control it was to get rid of it from within the birds,” he said. That meant vaccines and other measures “to ensure that if we get a positive flock, we don’t allow that to be spread to other flocks,” he said.
Some turkey companies had already taken desperate measures to stop the spread, euthanizing entire breeding flocks. It’s a practice that’s almost unheard of in the U.S. because of the cost but commonly practiced in some European countries to fight salmonella.
“That’s the point they got to in some of these companies, where they just didn’t have a choice anymore,” said Johnson.
The aggressive measures, along with intense surveillance and a vaccine breakthrough, would help turn the tide of the outbreak.
Inside Confinement Rearing Room 19 at the University of Minnesota’s Poultry Teaching and Research Facility in St. Paul, the 6-week-old turkeys chirped softly in their pens. Anup Johny, a food safety microbiologist, opened a wire-cage door to one of the pens, knelt in the wood shavings and cradled one of the birds.
Credit:
Jenn Ackerman + Tim Gruber
The size of footballs and covered in white feathers, the turkeys were test subjects in a research project to make food safer. In about six weeks, the turkeys would be removed from the pen and given Reading to assess the effectiveness of a vaccine, combined with a bacteria used in cheesemaking, against the pathogen.
The goal, said Johny, is to develop strategies to fight emerging salmonella strains should they ever become a problem in the future.
“It’s just like devising tools before an outbreak occurs,” he said.
The USDA recently announced that it’s rethinking its approach to salmonella in an effort to reduce an illness rate that hasn’t gone down in 25 years. Last month, the agency asked a key advisory committee for suggestions on how to improve its testing program to focus more on public health risks and on efforts to control the bacteria on farms. In early December, it also asked poultry companies for proposals to test new strategies for reducing contamination.
A close look at how the turkey industry controlled Reading and the ongoing work in Minnesota might provide critical clues.
As the Reading outbreak unfolded, turkey companies began developing custom vaccines and started testing if a commercially available vaccine developed for other types of salmonella could also protect turkeys against Reading.
Elanco Animal Health, which makes that vaccine, said it found that vaccinating newborn birds reduced Reading in ground turkey samples by 57%.
Michelle Kromm, vice president of animal health and welfare at Jennie-O, said the company had also seen reductions in Reading using the vaccine along with other measures. In the fall of 2018, it started vaccinating breeder flocks against Reading. It stopped reusing poultry litter, which lines barn floors, and started fumigating targeted barns between flocks. Later, it also began vaccinating the turkeys raised for food. In 2019, it required breeders to meet certain salmonella standards. And beginning last year, whenever Jennie-O detects Reading in flocks, it sends them to be made into cooked products to kill the bacteria.
“When we started seeing the birds that were able to have that whole program as part of their rearing process, we really started to see reductions pretty quickly,” Kromm said.
Since 2018, the percentage of Jennie-O ground turkey samples with Reading has fallen more than 90%, USDA records show.
Public health officials are hesitant to declare victory just yet given how COVID-19 has affected food poisoning statistics, but available data is pointing in the right direction. Wallenda Picard cautioned that no vaccine can protect against all strains.
Indeed, while available vaccines have been shown to have some success with infantis, the chicken industry has struggled to make a dent.
Alarmingly, while the strain has typically been found in chicken, it recently crossed into turkey, Johnson said. So with USDA funding, the University of Minnesota researchers are now setting their sights on infantis, using the same tools they used on Reading. If the approach works, it may one day end the infantis outbreak, which the CDC has deemed an epidemic.
Meanwhile, the team is continuing to test bacteria samples from farms, looking for the next dangerous strain to arise. Thanks to their work on Reading, the researchers now have a web-based tool, where companies can upload a sample and quickly get an initial indication if a strain is potentially risky, Johnson said, which would then prompt lab tests to confirm.
That will allow companies to make changes on the farm to prevent new strains from spreading. And in the not-too-distant future, companies might be able to use handheld genome sequencers on farms to make decisions to prevent contaminated birds from ever making it onto store shelves.
In the end, Wallenda Picard said, Reading might have had a “silver lining” by forcing the industry to focus on finding and controlling new strains.
“We just don’t ever want to go through the surprise that Reading was again,” she said. “I don’t think anyone will be so surprised again. At least that’s my hope.”
Irena Hwang contributed data analysis and Mollie Simon contributed research.